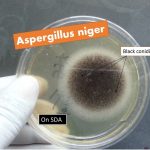
Aspergillus niger
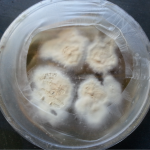
Trichophyton on SDA Dermatophyte growth on SDA: Introduction, culture, microscopic examination and lab diagnosis

Collection Group: Mycology
Aspergillus niger: Introduction, Pathogenicity, Laboratory Diagnosis and Treatment
Introduction of Aspergillus niger Aspergillus niger is one of the most...
Introduction of Aspergillus niger Aspergillus niger is one of the most...
Urease Positive Fungi: Introduction, List of Fungi and Test Procedure
 Introduction of Urease Positive Fungi Urease positive fungi can be...
Introduction of Urease Positive Fungi Urease positive fungi can be...
Dermatophyte Growth on SDA: Introduction, Culture, Microscopic Examination and Lab Diagnosis
Introduction of Dermatophyte Dermatophyte is a group fungus of three genera...
Introduction of Dermatophyte Dermatophyte is a group fungus of three genera...
